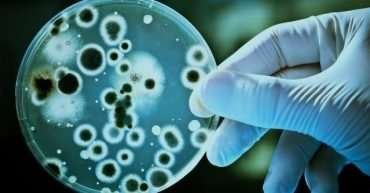

استراتيجيات تحقيق النجاح المهني: دليل شامل للتميز في العمل الأربعاء 26 حزيران 2024 النجاح في مجال العمل هو هدف يسعى إليه الجميع، سواء كانوا موظفين في بداية مسيرتهم المهنية أو مديرين ذوي خبرة. لكن ما هو النجاح في العمل؟ يمكن تعريفه بعدة طرق: التقدم الوظيفي، الرضا المهني، الثروة المالية، أو حتى التأثير الإيجابي في المجتمع. […]
السلامة في الأماكن المحصورة تزودك هذه الدورة التدريبية في الأماكن الضيقة بمهارات الصحة والسلامة المطلوبة للعمل في أماكن غير صالحة للسكن البشري. نحدد المخاطر المحتملة المرتبطة بالأماكن الضيقة ونشرح كيفية تقليلها. نوضح لك كيفية إجراء تقييمات المخاطر ومناقشة أنظمة تصاريح دخول الأماكن الضيقة، وإجراءات مراقبة الغلاف الجوي، ومعدات الإنقاذ في الأماكن الضيقة، وتقنيات الإنقاذ المستخدمة […]
أساسيات التعامل اليدوي في مكان العمل يقوم الجميع برفع الأشياء ودفعها وسحبها وحملها. تعلمك هذه الدورة كيفية التعامل اليدوي المناسب للحفاظ على صحة جيدة في بيئة العمل. نحن ننظر إلى التقنيات المختلفة ورفع الأثقال وخفضها بشكل آمن لكل من الرجال والنساء. تعرف على مخاطر أساليب الرفع السيئة، والوضعيات الصحيحة لرفع الأحمال، وقم بإجراء تقييمات المخاطر. […]
أساسيات التعلم الآلي هل ترغب في بناء أنظمة تتعلم من التجربة؟ أو استغلال البيانات لإنشاء نماذج تنبؤية بسيطة للعالم؟ في هذه الدورة التدريبية، التي تعد جزءًا من برنامج Data Science MicroMasters، ستتعلم مجموعة متنوعة من خوارزميات التعلم الخاضعة للإشراف وغير الخاضعة للإشراف، والنظرية الكامنة وراء تلك الخوارزميات. المدة: 10 أسابيع (8 ساعات أسبوعيًا)اللغة: الإنكليزيةالشهادة: يحصل […]
تحليلات لاتخاذ القرار هل تريد معرفة كيفية تجنب القرارات السيئة فيما يتعلق بالبيانات؟ إن اتخاذ قرارات جيدة باستخدام البيانات يمكن أن يمنحك ميزة تنافسية مميزة في مجال الأعمال. ستساعدك دورة الإحصاء وتحليل البيانات هذه على فهم المفاهيم الأساسية للتفكير الإحصائي السليم الذي يمكن تطبيقه في سياقات واسعة بشكل مدهش، حتى في بعض الأحيان حتى قبل […]
مقدمة CS50 لعلوم الكمبيوتر CS50x، مقدمة جامعة هارفارد للمؤسسات الفكرية في علوم الكمبيوتر وفن البرمجة للتخصصات وغير المتخصصين على حد سواء، مع أو بدون خبرة سابقة في البرمجة. دورة تدريبية للمبتدئين يدرسها David J. Malan، CS50x تعلم الطلاب كيفية التفكير الخوارزمي وحل المشكلات بكفاءة. تشمل المواضيع التجريد، والخوارزميات، وهياكل البيانات، والتغليف، وإدارة الموارد، والأمن، وهندسة […]
الاتصالات الرقمية أصبحت اتصالات الألياف الضوئية مجدية تجاريًا في السبعينيات، ولا يزال الابتكار مستمرًا حتى اليوم. ستوضح هذه الدورة التدريبية المجانية، الاتصالات الرقمية، كيف يمكن نقل معدلات بيانات عالية جدًا عبر مسافات طويلة عبر الألياف الضوئية. سوف تتعلم كيفية ربط هذه الألياف، وفحص التكنولوجيا المستخدمة وتقييم الاتجاه المستقبلي لمجال الاتصال الذي يتطور باستمرار. المدة: 20 […]
تصميم واجهة المستخدم: النص واللون والصور والصور المتحركة والصوت لماذا تعتبر الطريقة التي يبدو بها الشيء مهمًا؟ تتفاعل النصوص والألوان والصور والصور المتحركة والصوت لإنتاج بيئة سهلة الاستخدام داخل واجهة المستخدم. ستساعدك هذه الدورة التدريبية المجانية، تصميم واجهة المستخدم، على فهم تأثير كل مكون برمجي على المستخدم وشرح كيف يمكن للتطبيق المتسق والمدروس لهذه المكونات […]
البيانات والعمليات في الحوسبة ستساعدك هذه الدورة التدريبية المجانية، البيانات والعمليات في الحوسبة، على فهم أشكال البيانات التي يتم التعامل معها بواسطة البرامج وإلقاء نظرة على العمليات المختلفة التي يمكن تطبيقها على البيانات. يتم توضيح هذه الأفكار من خلال استخدام السوبر ماركت وتوضيح كيفية التعامل مع مجموعات البيانات البسيطة. المدة: 14 ساعةاللغة: الإنكليزيةالشهادة: يحصل الطالب […]
توسيع نطاق الأنشطة التجارية إلى بلدان أخرى هل تريد معرفة المتطلّبات اللازمة للانتقال بنشاطك التجاري إلى العالمية؟ ستتعرّف في هذه الدورة التعليمية على كيفية الدخول إلى أسواق جديدة وبيع منتجاتك إلى عملاء من مختلف أنحاء العالم. المدة: ساعةاللغة: الإنكليزيةالشهادة: يحصل الطالب على شهادة عند انهاء المراحل المطلوبةالرسوم: مجانًاالموقع:Google للتسجيل اضغط هنا
التحدّث أمام الجمهور لا تعتبر الخطابة العامة مهارةً تولد معنا، بل هي مهارة نكتسبها ولا تقتصر على فئة معينة من الناس، بل يمكن لأي شخص أن يتعلّمها. تركز هذه الدورة التدريبية المجانية على بعض لغات الجسد المهمة التي يمكن استخدامها عند إلقاء خطاب عام وخطوات التحضير اللازمة لتقديم خطاب يناسب جمهورك. المدة: ساعةاللغة: الإنكليزيةالشهادة: يحصل […]
الانتقال بالنشاط التجاري إلى عالم الإنترنت ستطلعك هذه الدورة على كلّ الخطوات اللازمة لإنشاء نشاط تجاري على الإنترنت وإدارته بنجاح، بالإضافة إلى كيفية بناء حضور قوي على الإنترنت والاستفادة من التجارة الإلكترونية وحماية نشاطك التجاري من المخترقين وجذب العملاء على الصعيد المحلي. المدة: 3 ساعاتاللغة: الإنكليزيةالشهادة: يحصل الطالب على شهادة عند انهاء المراحل المطلوبةالرسوم: مجانًاالموقع:Google […]
التقييم في الجغرافيا الثانوية ستحدد هذه الدورة المجانية، التقييم في الجغرافيا الثانوية، وتستكشف بعض القضايا الرئيسية حول تقييم الجغرافيا في المدارس الثانوية. من خلال فهم هذه القضايا والمناقشات، سوف تفكر في ممارسات التقييم الخاصة بك وتطورها كمدرس جغرافيا وتطور وعيًا أكبر بآثار ممارسة التقييم على أصول التدريس وما يعتبر ذا قيمة في تعليم الجغرافيا. المدة: […]
أساليب تطوير البرمجيات تقدم هذه الدورة المجانية، «أساليب تطوير البرمجيات»، منهجًا هندسيًا لتطوير أنظمة البرمجيات. تولي الدورة اهتمامًا خاصًا لقضايا جودة البرمجيات، من حيث المنتج (ما تم بناؤه) والعملية (كيف نبنيه). المدة: 9 ساعاتاللغة: الإنكليزيةالشهادة: يحصل الطالب على شهادة عند انهاء المراحل المطلوبةالرسوم: مجانًاالموقع:OpenLearn للتسجيل اضغط هنا
الإسبانية المتقدمة ستعمل هذه الدورة المجانية، «الإسبانية المتقدمة»، على تطوير معرفتك وفهمك للمجتمعات والثقافات في إسبانيا وأمريكا اللاتينية وتوسيع المهارات العملية للاستماع والتحدث والقراءة والكتابة. تركز الدورة على الطرق العديدة التي تتكيف بها اللغات الحية – وخاصة الإسبانية – مع السياقات التي تستخدم فيها. المدة: 4 ساعاتاللغة: الإنكليزيةالشهادة: يحصل الطالب على شهادة عند انهاء المراحل […]
الثدييات المائية تأتي الثدييات في مجموعة مذهلة من الأشكال والأحجام، ومع ذلك فإن جميع الأنواع البالغ عددها 4700 نوعًا تقريبًا لديها بعض الخصائص المشتركة، مما يبرر إدراج أنواع متنوعة ضمن مجموعة واحدة. على الرغم من أن الثدييات تطورت على الأرض، إلا أن عددًا من الأنواع قد تكيفت لقضاء جزء من حياتها أو كل حياتها في […]
الإسبانية المتقدمة: الفنون والحرف اليدوية تم تصميم هذه الدورة المجانية، الإسبانية المتقدمة: الفنون والحرف اليدوية، لتطوير معرفتك وفهمك للمجتمعات والثقافات الناطقة باللغة الإسبانية وتوسيع المهارات العملية للاستماع والتحدث والقراءة والكتابة. سوف تدرس عالم الفن الإسباني وأمريكا اللاتينية وتستكشف الفرق بين الفن والحرف. المدة: 12 ساعةاللغة: الإنكليزيةالشهادة: يحصل الطالب على شهادة عند انهاء المراحل المطلوبةالرسوم: مجانًاالموقع:OpenLearn […]
إمكانية الوصول إلى التعلم الإلكتروني إنه جزء من مهارات التدريس المهني لفهم احتياجات مجموعة متنوعة من الطلاب. تقدم هذه الدورة التدريبية المجانية، إمكانية الوصول إلى التعلم الإلكتروني، التحديات التي يواجهها الطلاب المعوقون الذين قد يستخدمون أجهزة الكمبيوتر بطرق مختلفة عند المشاركة في التعلم الإلكتروني أو قد يحتاجون إلى طرق تدريس بديلة. ويغطي التكنولوجيا والتقنيات المستخدمة […]
كيفية استخدام ChatGPT في الأعمال التجارية مرحبًا بك في كيفية استخدام ChatGPT في الأعمال التجارية! تم تصميم هذه الدورة لتعريفك بعالم ChatGPT المثير وكيف يمكنه تحويل الجوانب المختلفة للعمليات التجارية. سجل الآن للانضمام إلى هذه الرحلة المثيرة وشاهد كيف يمكن لـ ChatGPT أن ينقل عملك إلى المستوى التالي! المدة: ساعتيناللغة: الإنكليزيةالشهادة: يحصل الطالب على شهادة […]
كيفية استخدام ChatGPT في التكنولوجيا/الترميز/البيانات هل سئمت من قضاء ساعات في كتابة التعليمات البرمجية وتصحيح الأخطاء؟ هل ترغب في تبسيط سير عمل البرمجة لديك وتعزيز إنتاجيتك؟ لا تنظر إلى أبعد من كيفية استخدام ChatGPT في التكنولوجيا/الترميز/البيانات! في هذه الدورة، ستتعلم كيفية تسخير قوة ChatGPT لإحداث ثورة في عملية البرمجة الخاصة بك. بدءًا من التفكير وحتى […]
رواية قصص البيانات باستخدام جداول البيانات الحالية ومهارات التفكير الكمي، سيجعل المتعلمون بياناتهم تحكي قصة. تعتبر هذه الدورة مثالية للمتعلمين الذين بدأوا للتو في حياتهم المهنية، والصحفيين الذين يتطلعون إلى توسيع مجموعة مهاراتهم، والمسوقين الذين يتطلعون إلى رواية قصة. المدة: 4 أسابيع (20-40 ساعة أسبوعيًا)اللغة: الإنكليزيةالشهادة: يحصل الطالب على شهادة (مدفوعة) عند انهاء المراحل المطلوبةالرسوم: […]
التواصل الفعّال تعلم كيف يمكن لمهارة التواصل أن تساعدك في التحكم في مهنتك والعثور على عمل أو توسيع نطاق عملك. سواء كنت تدير أعمالاً أو تتطلع لتحقيق خطوة مهنية قادمة أو تبحث عن عمل، يمكن للشبكات أن تساعدك في التحكم في مسيرتك المهنية. ستمكنك هذه الدورة التدريبية المجانية من بناء شبكتك وعلامتك التجارية الخاصة، على […]
إدارة مشروع بواسطة أدوات رقمية إذا كنت صاحب مشروع أو تنوي تنفيذ مشروع، ستساعدك هذه الدورة التدريبية في تعلّم كيفية إدارة جميع جوانب مشروعك من الألف إلى الياء باستخدام الأدوات الرقمية. ليست إدارة المشاريع بالأمر السهل، خاصةً إذا كان المشروع كبيرًا ومعقدًا ويتضمّن العديد من الجوانب. لن تستطيع إدارته من خلال الكتابة على الورق فقط، […]
أساسيات التسويق الرقمي تعرَّف على أساسيات التسويق الرقمي من خلال دورة Google التدريبية المجانية المعتمدة من مكتب Interactive Advertising Bureau في أوروبا وجامعة The Open University. تتضمّن هذه الدورة 26 وحدة تعليمية من إعداد مدرّبين معتمدين لدى Google وتشمل مجموعة من التمارين العملية والنماذج الواقعية لمساعدتك على اكتساب المزيد من المعرفة وترجمتها على أرض الواقع. […]
اللغة الإنجليزية للتطوير الوظيفي تم تصميم هذه الدورة للمتحدثين باللغة الإنجليزية غير الناطقين بها والذين يرغبون في تطوير حياتهم المهنية في السوق العالمية. في هذه الدورة، ستتعرف على عملية البحث عن وظيفة وتقديم الطلبات وإجراء المقابلة في الولايات المتحدة، مع مقارنة نفس العملية في بلدك الأصلي. ستمنحك هذه الدورة أيضًا الفرصة لاستكشاف مسارك المهني العالمي، […]
الشهادة المهنية لمحلل بيانات Microsoft Power BI في هذه الدورة ستتعلم كيفية استخدام Power BI للاتصال بمصادر البيانات وتحويلها إلى رؤى مفيدة. وستقوم بإعداد بيانات Excel للتحليل في Power BI باستخدام الصيغ والوظائف الأكثر شيوعًا في ورقة العمل. وستتعلم كيفية استخدام إمكانات التصوير والتقرير في Power BI لإنشاء تقارير ولوحات معلومات مقنعة. وستظهر مهاراتك الجديدة […]
الذكاء الاصطناعي التوليدي لتخصص علماء البيانات في هذه الدورة ستتعلم كيفية تطبيق المهارات للتعرف على استخدامات الذكاء الاصطناعي التوليدي في العالم الحقيقي وتحديد نماذج وأدوات الذكاء الاصطناعي التوليدي الشائعة للنص والرمز والصورة والصوت والفيديو، وستفهم المفاهيم والأمثلة والأدوات الشائعة لهندسة الذكاء الاصطناعي التوليدية وتتعلم التقنيات لإنشاء مطالبات فعالة ومؤثرة، وستتعرف على كيفية تحديد أدوات الذكاء […]
مقدّمة عن اتصالات الأعمال تشمل الكتابة في مجال الأعمال أي وسيلة اتصال مكتوبة تُستخدم ضمن سياق مهني. إذ يمكن أن تكون على هيئة رسالة إلكترونية أو مذكّرة أو عرض تقديمي أو تقرير. في هذه الدورة التدريبية المجانية، ستتعلم بعض النصائح والتوجيهات التي من شأنها أن تساعدك في التواصل في بيئة العمل بشكل مباشر وسهل وواضح. […]
مقدّمة عن أساسيات الرموز البرمجية تقدّم تكنولوجيا تعلُّم الآلة إمكانيات لا تُحصى لتعزيز الفعالية والإنتاجية، سواء كان الهدف منها اقتراح الأفلام أو مساعدة العلماء في اكتشاف علاجات جديدة. ستتعرَّف في هذه الدورة على مفهوم تعلّم الآلة وكيفية تطبيقه في الحياة اليومية لتنمية الأنشطة التجارية. المدة: 20 دقيقةاللغة: الإنكليزيةالشهادة: يحصل الطالب على شهادة عند انهاء المراحل […]
مقدّمة عن أساسيات الرموز البرمجية لغة الرموز هي اللغة الأساسية التي تعتمدها كل الآلات كأجهزة الكمبيوتر وآلات البيع والسيارات، ولكن كيف تعمل هذه الرموز؟ ستتعلّم في هذه الدورة عن الرموز وسبب توفّر العديد من لغات الترميز وكيفية مطابقتها لتحقيق مهمّة معيّنة، والأهم من ذلك أنّك ستتعلّم أساسيات الرموز ومدى أهميتها بالنسبة إليك. المدة: ساعةاللغة: الإنكليزيةالشهادة: […]
أزمة الطفولة المبكرة والصدمات في هذه الدورة التدريبية المجانية، ستتعلم كيفية تعريف مصطلحات مثل (الكوارث) و(الأزمة)، والتعرف على آثار الصدمة وشرح التفاعل بين الأطفال، وتصنيف ردود الفعل المؤلمة الشائعة … المدة: 4 ساعاتاللغة: الإنكليزيةالشهادة: يحصل الطالب على شهادة عند انهاء المراحل المطلوبةالرسوم: مجانًاالموقع: Alison للتسجيل اضغط هنا Alison دورات
يدعوكم مركز MINE & GIL South لحضور دورات 2024 الخميس 15 شباط 2024 يدعوكم Center MINE & GIL South لحضور دورات 2024 (التسجيل مسبق). احجز مقعدك لدورات 2024، والتي ستغطي: – ريادة الأعمال – المعرفة المالية – الإقناع – المهارات الأساسية والحياتية سجل الآن Center MINE GIL South دورات
HIPAA Compliance: دليل كامل تعرف على كيفية الحفاظ على خصوصية البيانات الطبية والامتثال لقانون HIPAA في هذه الدورة التدريبية المجانية لإدارة الرعاية الصحية عبر الإنترنت. يجب على مسؤولي الرعاية الصحية حماية البيانات الطبية للحفاظ على خصوصية مرضاهم. يستكشف هذا المقرر قانون قابلية نقل التأمين الصحي والمساءلة (HIPAA) ويشرح كيفية تأثيره على صناعة الرعاية الصحية. نوضح […]
حماية الأطفال والبالغين الضعفاء في هذه الدورة التدريبية المجانية، ستتعلم كيفية مناقشة الحاجة إلى حماية الطفل… التعرف على العلامات المختلفة للإساءة في … التمييز بين الأنواع المختلفة … تحليل مختلف العلامات القصيرة والطويلة… المدة: 3 ساعاتاللغة: الإنكليزيةالشهادة: يحصل الطالب على شهادة عند انهاء المراحل المطلوبةالرسوم: مجانًاالموقع: Alison للتسجيل اضغط هنا
نظام إدارة المعلومات يقدم هذا المقرر لمحة شاملة عن نظام المعلومات الإدارية. تغطي موضوعات مثل تطوير نظام المعلومات، وهيكل وأهمية نظم المعلومات الإدارية، وأنواع أنظمة معالجة المعاملات (TPS)، وأنظمة أتمتة المكاتب (OAS) وأنظمة دعم القرار المختلفة. كما يستكشف نماذج نظم المعلومات الإدارية وتطبيقات البرامج مثل Microsoft Dynamics وExcel وأساسيات الأمن السيبراني، وتزود الدورة المتعلمين برؤى […]
أساسيات المفاهيم المتوسطة والمتقدمة في SQL تستكشف الدورة التدريبية على نطاق واسع تقنيات الاستعلام عن قاعدة البيانات، وتتضمن وظائف مثل Count، وSum، وMin، وMax، وAvg، وGroup By، والجملة، مع التدريب العملي على الوظائف المجمعة. إنه يتعمق في الانضمامات بشكل شامل، ويفحص الأنواع المختلفة من خلال الفهم النظري والجلسات المعملية العملية. علاوة على ذلك، فإنه يوضح […]
إدارة الأعمال تتكون هذه الدورة من 4 وحدات تغطي المجالات الوظيفية الأساسية للإدارة – التسويق، وإدارة الموارد البشرية، والإدارة المالية، وإدارة العمليات. من خلال كل وحدة، ستغطي الدورة المفاهيم والأطر الأساسية والضرورية. بحلول نهاية هذه الدورة، من المتوقع أن يكون لدى المتعلم قبضة أقوى على أساسيات الإدارة وأن يكون في وضع أفضل لوضع إستراتيجيات وقرارات […]
المهارات البحثية تم تصميم الدورة هذه لإثراء معرفتك بإجراء البحوث. ستساعدك الدورة على التقدم من أساسيات البحث إلى فلسفة ومنهجية البحث، بما في ذلك البيانات الكمية والنوعية. ستقدم هذه الدورة رؤى قابلة للتنفيذ للمتعلمين حول اختيار منهجية البحث قبل بدء مشروع بحثي والتعرف على أهمية تحليل البيانات في البحث. تعد الدورة خيارًا مثاليًا للمتعلمين الذين […]
أساسيات المباني وأعمال البناء يتضمن البناء تصميم وبناء بيئة مبنية من حولنا – ليس فقط ناطحات السحاب وملاعب كرة القدم والجسور، ولكن أيضًا المنازل والمصانع والمستشفيات والمدارس والسكك الحديدية والأنفاق والسدود والدفاعات الساحلية ومحطات توليد الطاقة. يقدم هذا المقرر تفاصيل حول التصنيفات وأنواع المباني المختلفة، والتكاليف المختلفة للمبنى وعوامل التصميم التي تؤثر على تكلفة المبنى. […]
الدبلوم التنفيذي في قوانين الإنترنت ستساعدك هذه الدورة على تطوير فهم شامل للفضاء الإلكتروني وكيفية العمل فيه. سيتم تعريفك أولاً بالفضاء السيبراني: الإنترنت وإدارة البيانات والجرائم السيبرانية. تعرف بالتفصيل على مختلف التهديدات والجرائم الإلكترونية والقوانين واللوائح التي تحكمها. تعد التجارة الإلكترونية أحد الأنشطة الرئيسية للأعمال الإلكترونية العاملة في الفضاء الإلكتروني. من خلال هذه الدورة، يمكنك […]
أساسيات Microsoft POWER BI الدورة عبارة عن دليل خطوة بخطوة يمكّن المتعلمين من استخدام أدوات Power BI لتصور البيانات التفاعلية. سيساعدك ذلك على التعرف على أساسيات دمج مصادر البيانات، والتنقل في نماذج البيانات، واستخدام برامج تحرير الاستعلام. إنه بمثابة دليل للمبتدئين لتحويل مجموعات البيانات الكبيرة إلى لوحات معلومات لإعداد التقارير والكشف عن الرؤى. تعد هذه […]
إتقان سلوك المستهلك – الشخصية والمواقف وأسلوب الحياة تقدم هذه الدورة رحلة شاملة إلى عالم سلوك المستهلك وتفاعله الديناميكي مع التسويق. سوف تستكشف كيف يؤثر المستهلكون على استراتيجيات التسويق، وبالتالي، كيف يمارس التسويق تأثيره على المستهلكين. من خلال التعمق، سنقوم بتشريح تعقيدات التحفيز والمواقف ومفهوم الذات، والكشف عن أدوارها المحورية في تشكيل قرارات المستهلك. من […]
سلوك المستهلك تقدم هذه الدورة لمحة شاملة عن سلوك المستهلك وتأثيره العميق على استراتيجيات التسويق. وتغطي المفاهيم الأساسية لسلوك المستهلك، واستكشاف العوامل الداخلية مثل الدافع والموقف ومفهوم الذات التي تشكل قرارات الشراء. وتتناول الدورة أيضًا الاعتبارات الأخلاقية وحقوق المستهلك والمشهد المتطور للنزعة الاستهلاكية. من خلال هذه الدورة، سوف يكتسب المتعلمون نظرة ثاقبة حول أنواع مختلفة […]
الدبلوم التنفيذي في الاتصالات التجارية تغطي الدورة موضوعات رئيسية مثل التواصل بين الأشخاص والتفاهم بين الثقافات وكتابة التقارير، وتوفر رؤى عملية تنطبق على مكان العمل الحديث. تعمل الدروس والاختبارات التفاعلية على تعزيز التواصل الجماعي وحل النزاعات وكفاءة الاجتماعات. مثالية للمدراء والمدراء التنفيذيين ورجال الأعمال، هذه الدورة الشاملة تعزز القدرة على التكيف في بيئات متنوعة. سوف […]
التسويق الرقمي والتجارة الإلكترونية هذا هو طريقك إلى مهنة التسويق الرقمي. ستتعلم في هذا البرنامج المهارات المطلوبة التي ستجعلك جاهزًا للعمل في أقل من 6 أشهر. وستتعلم قياس أداء التسويق من خلال التحليلات وتقديم الأفكار. لغة الدورة: الإنجليزيةمدة الدورة: ستة شهور (10 ساعات أسبوعيًا)الدرجة: مبتدأالرسوم: مجانًاالموقع: غوغل يحصل الطالب على شهادة يمكنه إدراجها في السيرة […]
إدارة الصحة والسلامة البيئية إدارة الصحة والسلامة البيئية هي دورة ستعلمك أهمية الصحة والسلامة في بيئة العمل. تعلمك الدورة أنواع المخاطر التي يمكن أن تحدث في أي مكان عمل وكيف يمكنك منعها أو تجنبها بشكل فعال. تعد إدارة السلامة والصحة في بيئة العمل مهمة صعبة ولكن من خلال هذه الدورة، يمكنك تعلم كيفية ضمان السلامة […]
خدمات الدعم الفني في مجال تكنولوجيا المعلومات تعلم في هذه الدورة كيفية أداء مهام دعم تكنولوجيا المعلومات اليومية بما في ذلك تجميع الكمبيوتر والشبكات اللاسلكية وتثبيت البرامج وخدمة العملاء، وتعلم كيفية استخدام الأنظمة بما في ذلك Linux وأنظمة أسماء المجالات وواجهة سطر الأوامر والرمز الثنائي، وتعرّف على كيفية توفير دعم شامل للعملاء، بدءًا من تحديد […]
إدارة المشاريع ستتعرف في هذه الدورة على كيفية إنشاء وثائق مشروع فعالة وأدوات خلال المراحل المختلفة للمشروع، وعلى كيفية ممارسة التواصل الاستراتيجي وحل المشكلات وإدارة الأطراف المعنية من خلال سيناريوهات واقعية، وستتعلم أسس إدارة المشاريع الرشيقة، مع التركيز على تنفيذ أحداث سكرم، وبناء أدوات سكرم، وفهم أدوار سكرم، وستكتسب فهم كبير للممارسات والمهارات اللازمة للنجاح […]
تصميم تجربة المستخدم تساعد هذه الدورة في فهم أساسيات بحث تجربة المستخدم، مثل تخطيط الدراسات البحثية وإجراء المقابلات ودراسة قابلية الاستخدام وتوليف نتائج البحث، وتساعد في اتباع عملية التصميم: تعاطف مع المستخدمين، وحدد الشكاوي، وابتكار الحلول، وإنشاء إطارات سلكية ونماذج أولية، واختبار التصميمات وتكرارها. لغة الدورة: العربيةمدة الدورة: خمسة شهور (10 ساعات أسبوعيًا)الدرجة: مبتدأالرسوم: مجانًاالموقع: […]
البدء بتدريس علوم البيانات في المدارس سيكون فهم كيفية استخدام البيانات وتفسيرها أمرًا ضروريًا للجيل القادم، ولكن العديد من المدارس والمدرسين ليسوا مجهزين لتدريس علوم البيانات الأساسية للطلاب. ستساعدك هذه الدورة على تقديم علم البيانات في الفصل الدراسي حتى يكون طلابك مستعدين للمستقبل. سوف تحصل على مقدمة للأدوات المفيدة لاستكشاف البيانات، وتعلم أساسيات الإحصاء واستكشاف […]
فهم التوحد يعاني الأشخاص المصابون بالتوحد من العالم بطرق مختلفة عن الأشخاص غير المصابين بالتوحد. وهذا يشمل الاختلافات في التواصل والخبرات الحسية. يمكن لهذه الاختلافات في كثير من الأحيان أن تضر الأشخاص المصابين بالتوحد أثناء تنقلهم في العالم غير المصاب بالتوحد. سوف يتشارك جميع الأشخاص المصابين بالتوحد في هذه الاختلافات الرئيسية ولكن قد يبدو هذا […]
كيفية جمع التبرعات: دليل لجمع التبرعات لغير جامعي التبرعات في هذه الدورة، ستحصل على نصائح عملية حول كيفية جمع التبرعات سواء كنت تعمل في مؤسسة غير ربحية أو خيرية، أو كنت متطوعًا في منظمة مجتمعية. باستخدام أبحاث جمع التبرعات القائمة على الأدلة، ستتعرف على من يقدم وكيف يفعل ذلك ولماذا يفعل ذلك. أثناء استكشافك لعملية […]
ادارة الموارد البشرية تغطي هذه الدورة نطاق أنشطة الموارد البشرية (HR) والسلوك التنظيمي (OB) التي يحتاج جميع محترفي الأعمال إلى فهمها: التخطيط الاستراتيجي، والتوظيف، والتوظيف والاختيار، وإدارة الأداء، والتدريب، والتعويضات. سوف تتعلم أيضًا أهم الأساليب التحفيزية – مثل «التسلسل الهرمي للاحتياجات» لماسلو، و«نظرية العاملين» لهيرزبرج وغيرها من النماذج الشائعة. علاوة على ذلك، تتضمن هذه الدورة […]
الاقتصاد والأعمال الدولية تقدم هذه الدورة المفاهيم الاقتصادية الأساسية التي تعتبر أساسية لفهم العديد من القضايا التي تواجهها شركات الأعمال. تعلّم العمليات التي تحكم إنتاج واستهلاك السلع والخدمات في الاقتصاد العالمي: الاقتصاد الجزئي والاقتصاد الكلي. هذه الدورة تساعدك على فهم مبادئ مهمة مثل مرونة الأسعار وقانون العرض والطلب. تتضمن هذه الدورة أيضًا الأنظمة الاقتصادية المختلفة […]
المهارات الإدارية الأساسية في عالم الأعمال اليوم، تعد المهارات الإدارية والقيادية ضرورية لتحقيق النجاح على المدى الطويل. تعلمك هذه الدورة كيفية إدارة المنظمات وتمكين الأفراد. سوف تتعلم نماذج القيادة المختلفة، وتكتشف أساليب القيادة المختلفة وتفهم كيفية تطور الفرق.سوف تتعلم أيضًا أساسيات إدارة المشاريع وإدارة التغيير وإدارة الوقت. علاوة على ذلك، ستعلمك هذه الدورة كيفية اتخاذ […]
التسويق والإتصالات ستتعلم في هذه الدورة كيفية إنشاء وتقديم وتوصيل قيمة المنتج لعملائك وبناء علاقات قوية مع العملاء.تتضمن مجموعة الارتباطات اللازمة لإدارة التسويق الناجحة التقاط رؤى تسويقية، والتواصل مع العملاء، وبناء علامات تجارية قوية، وتشكيل عروض السوق، وتقديم القيمة وتوصيلها، وخلق نمو طويل الأجل، وتطوير استراتيجيات وخطط التسويق. ستساعدك الأدوات المهمة، مثل مصفوفة BCG ومصفوفة […]
الحركة في بعدين تعمل هذه الدورة على توسيع مفاهيم الحركة من بعد واحد إلى بعدين. هناك تطبيقان رئيسيان لهذا المفهوم هما حركة البندول والقذيفة. وتختتم الدورة بأسئلة تختبر فهم الموضوع. اللغة: الإنجليزيةالمدة: 9 مراحلالشهادة: يحصل الطالب على شهادة بعد انهاء المراحل المطلوبةالموقع: labxchange للتسجيل اضغط هنا
الحرارة وطرق نقلها في هذه الدورة، يتم استخدام أفكار درجة الحرارة والطاقة الحرارية لفحص وتعريف الحرارة، وكيفية تأثر الحرارة بالخصائص الحرارية للمواد، وكيفية عمل الآليات المختلفة لنقل الحرارة. اللغة: الإنجليزيةالمدة: 14 مرحلةالشهادة: يحصل الطالب على شهادة بعد انهاء المراحل المطلوبةالموقع: labxchange للتسجيل اضغط هنا
العمل والطاقة والآلات البسيطة تستكشف هذه الدورة المفهوم الأساسي للطاقة، وكيف يمكن نقل الطاقة بين الأشياء. يتم تعريف أنواع الطاقة المختلفة، ويتم شرح قانون الحفاظ على الطاقة. يتم شرح الآلات البسيطة كوسيلة لتسهيل نقل الطاقة بين الأشياء. يتم توفير المشاكل للتحقق من الفهم. اللغة: الإنجليزيةالمدة: 11 مرحلةالشهادة: يحصل الطالب على شهادة بعد انهاء المراحل المطلوبةالموقع: […]
الموجات ونقل الطاقة تقدم هذه الدورة مفهوم الموجات. ويتم تعريف خصائص الموجات، مثل التردد والطول الموجي والفترة. يتم تقديم أمثلة على الموجات في الوسائط المختلفة، بالإضافة إلى الخصائص التي يمكن ملاحظتها. ويتم أيضاً توفير أسئلة للتحقق من الفهم. اللغة: الإنجليزيةالمدة: 8 مراحلالشهادة: يحصل الطالب على شهادة بعد انهاء المراحل المطلوبةالموقع: labxchange للتسجيل اضغط هنا
مقدمة إلى علم الخلايا تستكشف هذه الدورة الأنواع المختلفة من الخلايا، بما في ذلك الخلايا حقيقية النواة، وبدائية النواة، والخلايا النباتية، وبنيتها. اللغة: الإنجليزيةالمدة: 15 مرحلةالشهادة: يحصل الطالب على شهادة بعد انهاء المراحل المطلوبةالموقع: labxchange للتسجيل اضغط هنا
تغيرات مراحل الطاقة ترتبط التغيرات في الطاقة بالتغيرات الفيزيائية والكيميائية في الكيمياء. توفر هذه الدورة موارد لاستكشاف كيفية ارتباط الطاقة بهذه التغيرات، وكذلك التفاعلات الكيميائية. اللغة: الإنجليزيةالمدة: 16 مرحلةالشهادة: يحصل الطالب على شهادة بعد انهاء المراحل المطلوبةالموقع: labxchange للتسجيل اضغط هنا
المجالات المغناطيسية هذه الدورة تجعلك تستكشف المفاهيم الأساسية للمغناطيس والمجالات المغناطيسية. فيتم شرح العلاقة بين المغناطيس والمجالات التي ينتجها، بالإضافة إلى بعض التطبيقات المعاصرة للمغناطيسية في التشخيص الطبي وميكانيكا الكم. كما يتم توفير أسئلة للتحقق من الفهم. اللغة: الإنجليزيةالمدة: 11 مرحلةالشهادة: يحصل الطالب على شهادة بعد انهاء المراحل المطلوبةالموقع: labxchange للتسجيل اضغط هنا
علوم البيانات التطبيقية مع Python يوفر برنامج Data Science with Python للمتعلمين فهمًا كاملاً لأدوات وتقنيات تحليل البيانات. يمكن أن يساعدك البدء باستخدام Python في اكتساب المعرفة حول تحليل البيانات، والتصور، وNumPy، وSciPy، وتجريد الويب، ومعالجة اللغة الطبيعية. يعد هذا البرنامج بمثابة بداية مثالية لأي شخص يتطلع إلى أن يصبح عالم بيانات. اللغة: الإنجليزيةالمدة: 6 […]
مقدمة في علم البيانات ستساعدك دورة علوم البيانات المجانية هذه على فهم الأساسيات وكيف تصبح عالم بيانات. سوف تتعلم أفضل مكتبات بايثون لعلوم البيانات، وبعض خوارزميات علوم البيانات الأساسية، وأفضل وظائف ومهارات ومهارات علم البيانات. اتجاهات الرواتب. احصل على جميع المعلومات التي تحتاجها لبدء رحلتك التعليمية كمحترف في علوم البيانات. اللغة: الإنجليزيةالمدة: 7 ساعاتالشهادة: يحصل […]
تحليلات الأعمال مع Excel دورة تدريبية مجانية وهي مقدمة إلى تحليلات الأعمال باستخدام Excel للمبتدئين لتعزيز مهاراتك في Microsoft Excel. بما في ذلك دورة مقدمة إلى Power BI، سيقودك هذا البرنامج إلى طريق النجاح من خلال أساسيات تحليلات الأعمال. تعلم أساسيات تحليلات الأعمال مثل تحليل البيانات والإحصائيات لتعزيز مهارات اتخاذ القرار المستندة إلى البيانات. اللغة: […]
التفكير المفرط: تحسين التعلم والإبداع اليومي العالم يتغير بسرعة ومجرد اللحاق بالركب لا يكفي لتحقيق النجاح. يعرف الأشخاص الناجحون كيفية البقاء في صدارة الظروف المتغيرة. باستخدام أدوات التفكير الصحيحة، ويمكنك أن تبني هذه العقلية أيضًا! يساعدك HyperThinking على إدارة التحديات المختلفة: بدءًا من تقدير وجهات النظر المتناقضة وحتى إدارة الصراعات، ومن زيادة جودة الاجتماعات وفهم […]
البرمجة 101 لا يعرف معظم الأشخاص كيفية معالجة أجهزتهم الثنائية والتعامل مع البيانات، بدءًا من غسالتهم وحتى هواتفهم الذكية. ستكون هذه الدورة أساسًا واسعًا للمعرفة مما يوفر فهمًا لبعض الموضوعات التي يجب تغطيتها؛ مما يتيح لك أساسًا متينًا لتنمو منه. لا أعتقد أن فهم لغة البرمجة أولاً هو الطريقة الصحيحة للتعامل مع الأشياء. لقد تطورت […]
PowerPoint للمبتدئين – أساسيات البرامج والرسوم المتحركة هذه الدورة مخصصة للمصممين المبتدئين وعديمي الخبرة، الذين يطمحون إلى تعلم Microsoft PowerPoint للاستخدام المهني أو الخاص. لا يهم إذا كنت تريد إضافة مهارة جديدة إلى محفظتك، أو إنشاء مقاطع فيديو، أو إثارة الإعجاب في العمل، أو البدء في أن تكون رائد أعمال عبر الإنترنت. إذا كانت لديك […]
كيف تتحدث إلى أي شخص وتكون شجاعًا إذا كنت تتواصل مع أي شخص، وتريد أن تصبح رئيسًا أفضل أو زوجًا أو موظفًا مستقلاً أو في أي مجال تعمل فيه، فإن هذه الدورة ستساعدك بشكل كبير في جعلك متواصلاً أفضل بكثير.أهداف هذه الدورة بسيطة:أن تتعلم أساسيات التحدث أمام الجمهور، وتتعلم تقنيات متقدمة لتكون أكثر جاذبية ومحبوبًا […]
القانون الدولي إن التحديات المعقدة التي تواجه المجتمع العالمي تتطلب معرفة تتجاوز الحدود التخصصية. من خلال هذه الدورة في القانون الدولي، ستتعلم المجموعة الأساسية من القواعد المقبولة عمومًا باعتبارها ملزمة في العلاقات بين الدول وبين الأمم. سوف تتعلم كيف يعمل القانون الدولي كإطار لممارسة العلاقات الدولية المستقرة والمنظمة وكيف يختلف عن الأنظمة القانونية القائمة على […]
أساسيات الاستثمار لقد سمع الجميع عن سوق الأوراق المالية، ولكن كيف يعمل؟ كيف يمكن لأي شخص كسب المال من خلال الاستثمار؟ تجيب هذه الدورة على هذه الأسئلة وأكثر، وتستكشف كيف يمكن للاستثمار الدقيق أن يشكل مستقبلك المالي أو مستقبل شركتك.تعلم أساسيات الاستثمار ومركبات الاستثمار. اكتسب فهمًا لما يتطلبه البقاء واقفا على قدميه في سوق مضطرب، […]
مبادئ المحاسبة غالبًا ما تسمى المحاسبة المالية لغة الأعمال؛ إنها اللغة التي يستخدمها المديرون لتوصيل المعلومات المالية والاقتصادية للشركة إلى أطراف خارجية مثل المساهمين والدائنين. سواء كنت تدير مشروعك الخاص، أو تعمل كمدير، أو بدأت للتو حياتك المهنية، فأنت تريد فهم المعلومات المالية وتكون قادرًا على التفاعل مع المحاسبين والمراقبين والمديرين الماليين.ستزودك هذه الدورة بأساسيات […]
أساسيات إدارة الابتكار في هذه الدورة، ستقوم بتطوير عقلية مبتكرة وخبرة في كيفية نجاح الشركات في إنشاء أفكار جديدة لتسويق منتجات جديدة.يقدم هذا المقرر منهجًا تعليميًا سريعًا وفعالًا لإدارة الابتكار بهدف تزويد الطلاب بالقدرة على فهم القيمة الإستراتيجية للمعلومات والأدوات والتقنيات التي يمكن استخدامها لتحليل واستخدام تلك المعلومات لتحفيز الابتكار. اللغة: الانكليزيةمدة الدورة: ساعتينالشهادة: يحصل […]
تعليم اللغة الإنجليزية عن بعد هل حان الوقت لاتجاه جديد عبر الإنترنت في مسيرتك التعليمية؟ انضم إلى دورتنا التدريبية التي مدتها 4 أسابيع لتتعلم كيفية تكييف مهارات التدريس وجهًا لوجه مع بيئة الإنترنت.أصبح تدريس اللغة الإنجليزية عبر الإنترنت الآن ذا أهمية متزايدة في جميع أنحاء العالم، مما يمنح المتعلمين والمعلمين المرونة للعمل والتعلم أينما يريدون […]
إنتاج الأعلاف الحيوانية إن إنتاج الأعلاف الحيوانية بأمان سيضمن بقاء نظام الإنتاج الحيواني الخاص بك سليمًا. فالحيوانات التي تتغذى جيدًا لا تعيش لفترة أطول فحسب، بل إنها تتمتع بصحة أفضل وأكثر إنتاجية من حيث الجودة والكمية، مما يعني أرباحًا زراعية أكبر.في هذه الدورة، ستكتشف طرق التحكم والاختبار المستخدمة لتحقيق أقصى قدر من سلامة الأعلاف الحيوانية. […]
الطب في محيط العمليات الجراحية يموت الكثير من المرضى أو يعانون من مضاعفات طويلة الأمد بعد الجراحة.يعد الطب في محيط العمليات الجراحية نهجًا ناشئًا متعدد التخصصات يسعى إلى تحسين رعاية مرضى العمليات الجراحية المعرضين للخطر. ويشمل تخصصات مثل التخدير والجراحة والتمريض ورعاية المسنين والعلاج الطبيعي وإدارة الرعاية الصحية.في هذه الدورة التدريبية المعتمدة من RCoA، والتي […]
استخدام الأدوات الرقمية في تنفيذ المهام اليومية من المهم أن يكون لديك حساب على Google لأنه يوفر لك العديد من التطبيقات التي تساعدك في إنجاز مهامك اليومية وكذلك أعمالك. ومن أهم تلك التطبيقات التي يوفرها لك حساب Google: Gmail ومستندات Google وجداول بيانات Google والعروض التقديمية من Google. ستوضح لك هذه الدورة التدريبية كيفية استخدام […]
إنشاء سيرة ذاتية باستخدام مستندات Google كل شخص سواء كان يبحث عن عمل أو ما زال طالبًا يجب أن يمتلك سيرة ذاتية، لأنه سيحتاجها عند التقديم إلى وظيفة أو منح دراسية أو برامج تدريبية. وفي هذه الدورة التدريبية، ستتعلم كيفية إنشاء سيرة ذاتية وتتعرف على أقسامها الرئيسية، كما ستتعلم كتابة الرسالة التوضيحية، وتتعرف على رسائل […]
تطبيقات الذكاء الاصطناعي والهندسة السريعة تعلم كيفية إنشاء تطبيقات الذكاء الاصطناعي باستخدام الهندسة السريعة في هذه الدورة التدريبية التمهيدية عبر الإنترنت. تجاوز أساسيات الذكاء الاصطناعي، وتعلم المهارات التقنية والعملية لتسخير قوة هذه التكنولوجيا الناشئة. يوصى ببعض الخبرة في استخدام JavaScript وNode.js وAPIs. اللغة: الإنكليزيةالمدة: 10 ساعاتالرسوم: مجانًاالموقع: edx للتسجيل اضغط هنا
مقدمة إلى ChatGPT توفر هذه الدورة مقدمة عملية لـ ChatGPT، بدءًا من الاشتراك وحتى إتقان ميزاته المتقدمة. تشمل المواضيع التي يتم تناولها التحدث مع ChatGPT وتخصيصه واستخدامه للإنتاجية وبناء روبوتات الدردشة، بالإضافة إلى التطبيقات المتقدمة مثل ترجمة اللغة وإنشاء محتوى إبداعي. يتم أيضًا تضمين أفضل الممارسات والنصائح لاستخدام ChatGPT. اللغة: الإنكليزيةالمدة: ساعتينالرسوم: مجانًاالموقع: edx للتسجيل […]
الإستراتيجية والعمليات تعد الإدارة الإستراتيجية واحدة من أهم المهارات الصعبة في إدارة الأعمال. في الإدارة الإستراتيجية، سوف تتعلم كيف يمكنك إدارة الأعمال والمشاريع بشكل استباقي مع التركيز على الإستراتيجية طويلة المدى، بدلاً من الاستجابة للعثرات اليومية.من أجل القيام بذلك، سوف تتعرف على أهم أدوات الإدارة، مثل بيان الرؤية، وبيان المهمة، وتحليل PESTEL، والقوى الخمس لبورتر، […]
المالية والمحاسبة ستتعلم في هذه الدورة فهم لغة العمل – لقياس ومعالجة وتوصيل المعلومات المالية للشركات. ومن أجل القيام بذلك، سوف تتعرف على أهم البيانات المالية وتقنيات المحاسبة المالية. سوف تتعلم كيفية إعداد وتحليل الميزانيات العمومية وبيانات الدخل واستخدام النسب المالية. سوف تفهم مبادئ العائد على الأصول والعائد على حقوق الملكية. وسوف تتعلم أساسيات التمويل […]
تحسين محرك البحث (SEO) باستخدام Squarespace خلال هذه الدورة، سنقوم بتغطية التحسين على مستوى الموقع، والتحسين للبحث المحلي، وتحسين التدوين. ستغادر هذه الدورة وأنت تشعر بالثقة في قدرتك على استخدام الأدوات التي توفرها Squarespace لتحسين إمكانية البحث في موقعك. اللغة: الانكليزيةمدة الدورة: ساعتانالشهادة: يحصل الطالب على شهادة بعد انجاز المراحل كافةالموقع: Coursera تسجّل الآن
الإنتاجية: إدارة الوقت والتركيز والنجاح في هذه الدورة، سننتقل إلى الخلفية العلمية لاستراتيجيات التعلم وكيف يعمل التعلم والذاكرة وكيف يمكنك التحكم فيها واستخدامها لصالحك والقراءة السريعة وكيفية قراءة المزيد في وقت أقل مع ضمان الفهم المناسب للمحتوى. اللغة: الإنكليزيةمدة الدورة: 5 حصص الرسوم: مجانًاالموقع: Udemy للتسجيل اضغط هنا
اكتب روايتك الأولى في هذه الدورة، ستكتب روايتك الأولى. يقول الكثير من الناس إنهم غالبًا ما فكروا في كتابة رواية ويخططون للقيام بذلك يومًا ما، لكن القليل منهم يفعل ذلك بالفعل. ستتعلم كيفية تشكيل فكرة أساسية، أي فكرة، في هيكل وانضباط يسمح لك بإنشاء وكتابة وإكمال رواية كاملة على استعداد لتقديمها للنشر. اللغة: الانكليزيةمدة الدورة: […]
تعلم أساسيات لغة HTML هذه الدورة مثالية للمبتدئين لإنشاء صفحة الويب. تعلم إنشاء رمز HTML من الصفر. ستجد أنه من السهل البدء في HTML مع توفير جميع الموارد والروابط التي تحتاجها. يتم تضمين كل شيء لجعلك تبدأ بسرعة. اللغة: الإنكليزيةمدة الدورة: 3 حصص الرسوم: مجانًاالموقع: Udemy للتسجيل اضغط هنا
تحليلات البيانات من Google Professional Certificate تعلم المهارات التحليلية الأساسية (تنظيف البيانات وتحليلها ومؤثرات العرض) والأدوات (جداول البيانات، وSQL، وبرمجة R، وTableau). تعرّف على كيفية تصور مؤثرات عرض نتائج البيانات وتقديمها في لوحات المعلومات والعروض التقديمية والأنظمة الأساسية لمؤثرات العرض شائعة الاستخدام. لغة الدورة: العربيةمدة الدورة: 9 أشهر بمعدل 5 ساعات في الأسبوعالدرجة: مبتدأالرسوم: مجانًاالموقع: […]
التسويق الرقمي والتجارة الإلكترونية هذا هو طريقك إلى مهنة التسويق الرقمي. ستتعلم في هذا البرنامج المهارات المطلوبة التي ستجعلك جاهزًا للعمل في أقل من 6 أشهر. لا يشترط الدرجة العلمية أو الخبرة. لغة الدورة: الإنكليزية مدة الدورة: 6 أشهر بمعدل 10 ساعات في الأسبوعالدرجة: مبتدأالرسوم: مجانًاالموقع: غوغل يحصل الطالب على شهادة يمكنه إدراجها في السيرة […]
تعلم كيفية إنشاء موقع WordPress – PROFESSIONAL تحتوي هذه الدورة على كل ما تحتاجه لتصبح مطور WordPress!ستقودك هذه الدورة إلى كل ما تحتاج إلى معرفته للحصول على موقع WordPress وتشغيله حيث ستتعرف على كيفية INs وOUTs في WordPress. اللغة: الإنكليزيةمدة الدورة: 4 حصص الرسوم: مجانًاالموقع: Udemy للتسجيل اضغط هنا
برمجة 101 وستزودك هذه الدورة بقاعدة معرفية واسعة تعطي فهماً لبعض المواضيع التي يلزم تناولها، كما وتعطيك أساسًا صلبًا للنمو منه. فلا أؤمن بفهم لغة البرمجة أولاً هي الطريقة الصحيحة للقيام بالأشياء وقد تطورت لغات البرمجة كأداة لنا. اللغة: الإنكليزيةمدة الدورة: 7 حصص الرسوم: مجانًاالموقع: Udemy للتسجيل اضغط هنا
لغة التصميم: الشكل والمعنى ستقدم هذه الدورة معجمًا تتمكن من خلاله إظهار طرق أكثر وضوحًا ودراسة للحديث عن تصميم الجرافيك في سياق النقد. من خلال هذا المعجم وإطار النقد المقدم، سنقوم بنمذجة ثم نمارس بشكل موضوعي وصف مدى جودة عمل التصميم بناءً على معايير محددة ومفصلة بوضوح. من خلال تحسين هذه المهارة، ستعزز قدرتك على […]
الأسواق المالية تعطي الدورة نظرة عامة على الأفكار والأساليب والمؤسسات التي تسمح للمجتمع البشري بإدارة المخاطر وتعزيز المشاريع. التركيز على المهارات القيادية الذكية مالياً، حيث تصف الممارسات اليوم وتحليل آفاق المستقبل. مقدمة لمبادئ إدارة المخاطر والتمويل السلوكي لفهم الأداء الواقعي للأوراق المالية والتأمين والصناعات المصرفية. اللغة: الانكليزيةمدة الدورة: 7 مراحلالشهادة: يحصل الطالب على شهادة بعد […]
علم نفس الطفل – أهمية اللعب تناقش دورة علم النفس هذه النظريات النقدية التي تثبت أهمية اللعب للأطفال الصغار. ندرس تطور النظرية المعرفية وكذلك النظريات الحديثة المحيطة باللعب، ثم ندرس تأثير اللعب على كل مرحلة من مراحل نمو الطفولة المبكرة. نستكشف أيضًا العوامل التي تؤثر على سلوك اللعب في سنوات ما قبل المدرسة وتتبع تأثير […]
تعليم ذوي الاحتياجات الخاصة تقدم هذه الدورة أساسيات الاحتياجات التعليمية الخاصة. أولاً، نستكشف كيفية ارتباط الحاجة الخاصة بالإعاقة ونتعلم تصنيفها في مجالاتها الرئيسية الأربعة. بعد ذلك، سنستكشف عملية دعم وتقييم الحاجة الخاصة، بما في ذلك أهمية التدريس الجيد للطلاب الذين يعانون من هذه المشكلة. المدة: مرحلتاناللغة: الإنكليزيةالشهادة: يحصل الطالب على شهادة عند انهاء المراحل المطلوبةالرسوم: […]
القواعد والمفردات في اللغة الإنكليزية (مرحلة متقدمة) ستعلمك هذه الدورة المجانية للغة الإنجليزية عبر الإنترنت عن القواعد والمفردات المستخدمة عند مناقشة العمل. ستتعلم في هذه الدورة مناقشة مجموعة من الموضوعات المتعلقة بالعمل بالإضافة إلى الأفعال المهمة والتجمعات والأفعال العبارية وربط الكلمات والتعبيرات المستخدمة عند القيام بذلك. كما ستتعرف أيضًا على التطبيق الصحيح للجراثيم واللانهاية، والتي […]
التحكم بالغضب وحلّ النزاعات الغضب كغيره من المشاعر الانسانية، هو جزء من تجاربنا اليومية، وإذا لم تتم إدارته بشكل جيد، فقد يؤدي إلى آثار سلبية وانخفاض الإنتاجية. إنه عاطفة لا مفر منها تدل على عدم الرضا. من ناحية أخرى، إذا بقيت تحت السيطرة، يمكنك أن تعيش حياة كاملة وتتفاعل مع الآخرين بشكل بناء. تكشف هذه […]
تطور اللغة في مرحلة الطفولة تبحث هذه الدورة في تعريف «اللغة» والنظريات المختلفة لتطور اللغة حيث ندرس المصطلحات، مثل مفهوم «علم الأصوات» وعلاقته باللغة، كما تشرح الدورة بعد ذلك عوامل مختلفة تؤثر على نمو لغة الأطفال في سن مبكرة. المدة: 3 مراحلاللغة: الإنكليزيةالشهادة: يحصل الطالب على شهادة عند انهاء المراحل المطلوبةالرسوم: مجانًاالموقع: Alison للتسجيل اضغط […]
مقدمة إلى إمكانية الوصول إلى الويب ستحصل في هذه الدورة على لمحة عامة مفصلة عن سبب أهمية إمكانية الوصول إلى الويب، ومن يساعدك، ونوع التقنيات التي ينطوي عليها إنشاء واجهات يمكن الوصول إليها وكيفية تطبيق إرشادات إمكانية الوصول إلى محتوى الويب. المدة: 7 مراحلاللغة: الإنكليزيةالشهادة: يحصل الطالب على شهادة عند انهاء المراحل المطلوبةالرسوم: مجانًاالموقع: Alison […]
مقدمة إلى Adobe InDesign CC Adobe InDesign CC هي أداة تأليف شائعة لإنشاء الكتيبات والنشرات والمواد التسويقية. وبالتالي، فإن الكفاءة في برنامج التصميم هذا هي أحد الأصول الضخمة في سوق العمل اليوم حيث يشرح هذا البرنامج التعليمي InDesign كيفية ترتيب اللبنات الأساسية لمشاريع التصميم من خلال تدريس المفاهيم والممارسات التأسيسية. المدة: 3 مراحلاللغة: الإنكليزيةالشهادة: يحصل […]
دورة Adobe lightroom للمبتدئين ستتعلم في هذه الدورة المجانية عبر الإنترنت كل ما تحتاج لمعرفته حول إدارة الصور والتحرير في Adobe Lightroom Classic. تعرف على كيفية استيراد صورك وتنظيمها في المكتبة حتى تتمكن من موازنة الألوان والضوء والتفاصيل للحصول على أفضل جودة لكل صورة. المدة: 4 مراحلاللغة: الإنكليزيةالشهادة: يحصل الطالب على شهادة عند انهاء المراحل […]
مقدمة في تصميم التفكير التصميمي ستزودك هذه الدورة بنظرة عامة على التفكير التصميمي، الذي يُستخدم غالبًا في تجربة المستخدم/واجهة المستخدم وإدارة المنتجات، وفي جميع أنحاء الصناعات التكنولوجية. وستتعلم في هذه الدورة كيف يمكنك تطبيق منهجية مبتكرة تتمحور حول الإنسان وتضع العميل أولاً في عملك. اللغة: الإنكليزيةالمدة: أسبوعالرسوم: مجانًاالموقع: edx للتسجيل اضغط هنا
مقدمة في العلامة التجارية «ما هي العلامة التجارية ؟» ستتعلم كيف يمكنك استخدام مبادئها للتميز بشكل أفضل عن المنافسة. اللغة: الإنكليزيةالمدة: أسبوعالرسوم: مجانًاالموقع: edx للتسجيل اضغط هنا
مقدمة إلى بناء بورتفوليو وتحليله مع بايثون هذه الدورة متخصصة في علوم البيانات والتعلم الآلي في إدارة الأصول ولكن يمكن أخذها بشكل مستقل، فتغطي أساسيات علم الاستثمار، وستبني تطبيقات عملية لكل من المفاهيم على طول الطريق. اللغة: الانكليزيةمدة الدورة: 4 مراحل (24 ساعة)الشهادة: يحصل الطالب على شهادة بعد انجاز المراحل كافةالموقع: Coursera تسجّل الآن
التعلم الخاضع للإشراف وتطبيقاته في التسويق في هذه الدورة، ستستخدم لغة برمجة Python، وهي أداة فعالة لتطبيقات التعلم الآلي، وسيتم تعريفك بتقنيات التعلم الخاضعة للإشراف: الانحدار والتصنيف، حيث ستركز الدورة على تطبيقات هذه التقنيات في مجال التسويق. اللغة: الانكليزيةمدة الدورة: 12 مرحلة (21 ساعة)الشهادة: يحصل الطالب على شهادة بعد انجاز المراحل كافةالموقع: Coursera تسجّل الآن
التصميم والممارسة للمعلمين هذه الدورة مخصصة لمعلمي اللغة الذين يرغبون في تعلم كيفية بناء وتعليم دورة لغة مختلطة فقد تحصل على 1.5 ائتمانات لتعليم المعلمين (GRTE) لإكمال هذه الدورة، انظر أدناه لمزيد من المعلومات. اللغة: الانكليزيةمدة الدورة: 4 مراحل (20 ساعة)الشهادة: يحصل الطالب على شهادة بعد انجاز المراحل كافةالموقع: Coursera تسجّل الآن
تحليل السلوك التطبيقي ستقدمك هذه الدورة المجانية عبر الإنترنت إلى ABA والنظريات التي توجهها وقواعدها وتقنياتها، حيث تحتوي هذه الدورة أيضًا على عروض توضيحية مفصلة لكيفية استخدام تقنيات ABA المختلفة مثل التسلسل والنقوش. تعمل هذه التقنيات على تحسين المهارات الحركية والمهارات اللغوية والوظيفة المعرفية والمهارات البصرية المكانية. المدة: 3 مراحلاللغة: الإنكليزيةالشهادة: يحصل الطالب على شهادة […]
الممارسة العملية للترجمة تقدم لك هذه الدورة تقنيات أساسية ولكنها قيمة يستخدمها مترجم جيد في الترجمة بين الإنجليزية والصينية، حيث تناقش ما هي الترجمة وما هي الترجمة الجيدة وكيف ننتج ترجمات جيدة. اللغة: الانكليزيةمدة الدورة: 6 مراحل (23 ساعة)الشهادة: يحصل الطالب على شهادة بعد انجاز المراحل كافةالموقع: Coursera تسجّل الآن
أساسيات معالجة الصدمات يمكن أن تسبب الأحداث الكارثية اضطراب ما بعد الصدمة (PTSD)، مما يؤثر بشكل كبير على الأداء العاطفي والعقلي للأفراد، وهي مصدر قلق عالمي لأنظمة الرعاية الصحية. لذلك أنشأنا دورة معالجة الصدمات هذه لمنح المتخصصين في الصحة العقلية والأطباء الآخرين المعرفة والمهارات التي يحتاجونها لمساعدة المرضى والعملاء على تحديد ومعالجة التجارب المؤلمة التي […]
الدليل الشامل لفناني التعليق الصوتي تعلمك هذه الدورة كيفية تسجيل مقاطع صوتية احترافية عالية الجودة لمرافقة الكتب الصوتية وألعاب الفيديو والرسوم المتحركة والإعلانات التجارية والراديو، فتشرح الفرق بين التعليق الصوتي والتمثيل الصوتي وأدوار فناني التعليق الصوتي وغيرها من التقنيات الضرورية في التعليق الصوتي. المدة: مرحلتاناللغة: الإنكليزيةالشهادة: يحصل الطالب على شهادة عند انهاء المراحل المطلوبةالرسوم: مجانًاالموقع: […]
إدارة مكتب قانوني تعلمك هذه الدورة كيفية أداء مختلف إجراءات ووظائف مهنة المحاماة، فمن خلال إعداد المستندات القانونية والتقاضي والعقود بينما نستكشف أنواعًا مختلفة من القوانين، بما في ذلك الطلبات الجنائية والعائلية والتجارية والعقارية وطلبات الإفلاس. المدة: 14 مرحلةاللغة: الإنكليزيةالشهادة: يحصل الطالب على شهادة عند انهاء المراحل المطلوبةالرسوم: مجانًاالموقع: Alison للتسجيل اضغط هنا
كيفية كتابة الاقتباسات والمراجع والببليوغرافيا صممت دورة الكتابة الأكاديمية لمساعدة الطلاب والكتاب والباحثين على الامتثال لاتفاقيات النشر المتعلقة باستخدام المصادر في عملهم حيث تبدد المفاهيم الخاطئة الشائعة فيما يتعلق بهذه المصطلحات وتكشف تعقيدات أدلة الأسلوب وأنظمة إدارة المراجع لإعدادك للمتطلبات الغريبة للكتابة الأكاديمية. المدة: مرحلتان اللغة: الإنكليزيةالشهادة: يحصل الطالب على شهادة عند انهاء المراحل المطلوبةالرسوم: […]
فهم اضطرابات اللغة لدى الطفل اضطراب اللغة هو نوع من اضطراب الاتصال الذي يجعل من الصعب فهم اللغة والتعبير عنها ومعالجتها وقد تؤثر على النمو الاجتماعي والعاطفي والأكاديمي للأطفال. تغطي دورة علم نفس الطفل هذه النمو اللغوي الطبيعي وأشكال الاضطرابات اللغوية والحلول الممكنة للصعوبات اللغوية في مرحلة الطفولة. المدة: مرحلتان اللغة: الإنكليزيةالشهادة: يحصل الطالب على […]
تعليم الأطفال الصم توفر لك هذه الدورة معرفة ومهارات حول تعليم الأطفال الصم حيث ستتعرف على أهمية ثقافة الصم ومجتمعهم، والحاجة إلى بيئة غنية باللغة للطفل الأصم منذ صغره قدر الإمكان، وأن الوصول إلى لغة الإشارة يمكن أن يساعد الأطفال الصم أكاديميًا وعاطفيًا واجتماعيًا. اللغة: الانكليزيةمدة الدورة: 4 مراحل (15 ساعة)الشهادة: يحصل الطالب على شهادة […]
أساسيات المحاسبة توفر هذه الدورة اللبنات الأساسية للمحاسبة وتستخدم عمليات محاكاة تجارية مبتكرة لشرح مفاهيم مثل الإيرادات والتكاليف والأصول والخصوم حيث توضح لك كيف يخلق مبدأ «الاستحقاق» فرقًا أساسيًا بين الربح والتدفق النقدي وكيف تضمن مسك الدفاتر ذات القيد المزدوج أن يكون دفتر الأستاذ دائمًا متوازنًا. المدة: 6 مراحلاللغة: الإنكليزيةالشهادة: يحصل الطالب على شهادة عند […]
دبلوم في أساسيات كتابة الرسالة البحثية ستعرفك الدورة على النهج العملي خطوة بخطوة لتطوير وكتابة وتقسيم محتويات أطروحة حيث تتعلم أكثر الطرق فعالية لصياغة أطروحة من الفصل التمهيدي إلى الفصل الختامي. المدة: مرحلتان اللغة: الإنكليزيةالشهادة: يحصل الطالب على شهادة عند انهاء المراحل المطلوبةالرسوم: مجانًاالموقع: Alison للتسجيل اضغط هنا
مهارات متقدمة في الأبوة وتربية الأطفال ستعلمك هذه الدورة استراتيجيات وتقنيات متطورة يمكن أن تساعدك على أن تصبح أفضل والد يمكنك أن تكون. تتألف هذه الدورة من سلسلة من مقاطع الفيديو خطوة بخطوة لمنحك الثقة وأنت تواجه أهم مهمة في حياتك: تربية طفل سعيد ومستقر. المدة: 3 مراحل اللغة: الإنكليزيةالشهادة: يحصل الطالب على شهادة عند […]
درس شامل في وقاية ومكافحة العدوى ستتعلم فائدة اللقاحات كإجراء وقائي ضد العدوى، والوسائل المختلفة لانتقال العدوى وتدابير السيطرة على انتشار العدوى. المدة: مرحلتان اللغة: الإنكليزيةالشهادة: يحصل الطالب على شهادة عند انهاء المراحل المطلوبةالرسوم: مجانًاالموقع: Alison للتسجيل اضغط هنا
الطاقة الهوائية تقدم هذه الدورة لمحة عامة عن الجوانب الرئيسية في هندسة طاقة الرياح. سواء كنت تبحث عن رؤية عامة في هذه التكنولوجيا الخضراء أو طموحك هو متابعة مهنة في هندسة طاقة الرياح، فإن «طاقة الرياح» هي نقطة انطلاق ممتازة. اللغة: الانكليزيةمدة الدورة: 16 مرحلة (34 ساعة)الشهادة: يحصل الطالب على شهادة بعد انجاز المراحل كافةالموقع: […]
علاج الإدمان: المهارات السريرية لمقدمي الرعاية الصحية تهتم هذه الدورة بتحسين الرعاية التي تقدمها لمرضاك الذين يعانون من اضطرابات تعاطي المخدرات. من خلال الخوض في حالة نموذجية يقوم بها ممثلون، يوفر سبعة مدربين من مختلف المجالات تقنيات لفحص مرضاك بحثًا عن مخاطر اضطراب تعاطي المخدرات، وتشخيص المرضى لقياس شدة استخدامهم، وإدارة خطط العلاج بشكل مباشر، […]
معجزات اللغة الإنسانية: مقدمة الى اللسانيات تقدم هذه الدورة مقدمة في دراسة اللغات، مجال اللغويات. ، ستتمكن قريبًا من التعليق على كل من التنوع بين اللغات بدعم من المصطلحات اللغوية الأساسية التي يتم تقديمها في الدورة. اللغة: الانكليزيةمدة الدورة: 6 مراحل (21 ساعة)الشهادة: يحصل الطالب على شهادة بعد انجاز المراحل كافةالموقع: Coursera تسجّل الآن
الطب النفسي الإيجابي والصحة العقلية ستكتشف خلال هذه الدورة جوانب مختلفة من الصحة العقلية بالإضافة إلى تقديم نظرة عامة على الأنواع الرئيسية من الاضطرابات العقلية وأسبابها وعلاجاتها وكيفية طلب المساعدة والدعم. تضم الدورة عددًا من الخبراء الأستراليين في مجال الطب النفسي وعلم النفس، كم وستتعرف على أشخاصٍ عاشوا مع مرض عقلي سيروون تجاربهم الحقيقية. اللغة: […]
علم الأعصاب التطبيقي تضع هذه الدورة بين يديك مقدمة للطرق الأساسية الحاسوبية الأساسية لفهم ما تفعله الأجهزة العصبية وتحديد كيفية عملها كما ستتعرف خلال هذه الدورة على المبادئ الحسابية التي تحكم الجوانب المختلفة للرؤية والتحكم الحسي الحركي والتعلم والذاكرة، كما وتشمل الموضوعات المحددة التي سيتم تغطيتها تمثيل المعلومات عن طريق ارتفاع الخلايا العصبية، ومعالجة المعلومات […]
مقدمة الى تصور البيانات ستعلمك هذه الدورة كيفية فهم البيانات من خلال إنشاء تقارير ولوحات معلومات وجذابة. ستستخدم أدوات مثل Tableau وPower BI وExcel وR وPython لإنشاء تصورات. بعد اتمتم الساعات المطلوبة، سيكون لديك فهم واضح لكيفية استخلاص استنتاجات ذات مغزى من البيانات. اللغة: الإنكليزيةالمدة: 9 ساعاتالرسوم: مجانًاالموقع: Simple Learn للتسجيل اضغط هنا
مقدمة الى SQL ستغطي هذه الدورة موضوعات مهمة مثل MySQL و PostgreSQL و SQL Server، ووظائف SQL المدمجة، والإجراءات المنضمة والاستفسارات الفرعية المخزنة. اللغة: الإنكليزيةالمدة: 9 ساعاتالرسوم: مجانًاالموقع: Simple Learn للتسجيل اضغط هنا
مقدمة إلى تطوير الواجهة الأمامية تقدم هذه الدورة فهمًا شاملاً لمطوري الواجهة الأمامية الطموحين حول ما يدخل في تصميم أسلوب وواجهات المستخدم لمواقع الويب، وتساعد على تعلم تطوير الواجهة الأمامية من الصفر بالإضافة إلى الأدوات والتقنيات الرئيسية فيها. اللغة: الإنكليزيةالمدة: 12 ساعةالرسوم: مجانًاالموقع: Simple Learn للتسجيل اضغط هنا
أساسيات التسويق عبر انستغرام تساعدك هذه الدورة على زيادة متابعينك على انستغرام كما أنّها تحفز الوصول الى حسابك ووصول حسابك الى العدد الأكبر من المتابعين من خلال استخدام Instagram لعملك كأداة تسويق. ستغطي الدورة ذات شهادة Instagram Marketing المجانية هذه موضوعات حول كيفية استخدام علامات التصنيف المناسبة وكيفية كسب المال عبر الإنترنت من خلال Instagram […]
مقدمة في علم وظائف الأعضاء البشرية هذه الدورة هي فرصة للطلاب والمختصين في الرعاية الصحية وأي شخص مهتم بعلم وظائف الأعضاء البشرية وعلم الأحياء، بناءً على فهم أساسي لتشريح الإنسان، كما أنّها مورد ممتاز لإعداد MCAT أو لتنشيط المهنيين الصحيين. المدة: 11 مرحلةاللغة: الإنكليزيةالشهادة: يحصل الطالب على شهادة عند انهاء المراحل المطلوبةالرسوم: مجانًاالموقع: Alison للتسجيل […]
كيف تصمم مع Canva يعلم هذا البرنامج التعليمي من Canva المبتدئين كيفية استخدام منصة التصميم الجرافيكي القوية هذه لإنشاء محتوى مرئي مثل الملصقات ومواقع الويب والمزيد. المدة: 3 مراحلاللغة: الإنكليزيةالشهادة: يحصل الطالب على شهادة عند انهاء المراحل المطلوبةالرسوم: مجانًاالموقع: Alison للتسجيل اضغط هنا
مقدمة في تصميم الأنظمة المدمجة ستعلمك هذه الدورة التدريبية كيفية عمل هذه الأجهزة، والعمليات المتضمنة في تطويرها، والاختلافات بين الأنظمة المضمنة وأنظمة الكمبيوتر ذات الأغراض العامة. المدة: 7 مراحلاللغة: الإنكليزيةالشهادة: يحصل الطالب على شهادة عند انهاء المراحل المطلوبةالرسوم: مجانًاالموقع: Alison للتسجيل اضغط هنا
علم النفس الاجتماعي تقدم هذه الدورة مقدمة موجزة لعلم النفس الاجتماعي الكلاسيكي والمعاصر، وتغطي موضوعات مثل صنع القرار والإقناع والسلوك الجماعي والجذب الشخصي والعوامل التي تعزز الصحة والرفاهية. اللغة: الانكليزيةمدة الدورة: 7 مراحلالشهادة: يحصل الطالب على شهادة بعد انجاز المراحل كافةالموقع: Coursera تسجّل الآن
استراتيجية تسويق المحتوى ستتعلم في هذه الدورة الاستراتيجيات الأساسية التي يستخدمها مسوقو المحتوى لاكتساب العملاء والاحتفاظ بهم بشكل مربح. على وجه التحديد، ستتعلم كيفية تطوير وتنظيم وتنفيذ استراتيجية تسويق المحتوى، وتحليل وقياس فعالية تسويق المحتوى، وكتابة نسخة مقنعة، واستخدام إطار عمل استراتيجي عند الكتابة، وبناء علامتك التجارية المهنية وسلطتك من خلال تسويق المحتوى. اللغة: الانكليزيةمدة […]
أدوات وتقنيات في التكنولوجيا الحيوية: التحول البكتيري توضح هذه الدورة كيفية إضافة المعلومات الجينية إلى الخلايا في تقنية تسمى التحويل. المدة: 6 مراحلاللغة: العربيةالشهادة: يحصل الطالب على شهادة عند انهاء المراحل المطلوبةالرسوم: مجانًاالموقع: labXchange للتسجيل اضغط هنا
اضطراب طيف التوحد في مرحلة الطفولة المبكرة تستكشف هذه الدورة المجانية الشاملة وبائيات التوحد والمشاكل الحرجة التي يواجهها الأطفال المصابون بالتوحد وكذلك تناقش الأساليب المختلفة لتعليم الأطفال المصابين بالتوحد باستخدام استراتيجيات وتعديلات سلوكية مختلفة. المدة: مرحلتيناللغة: الإنكليزيةالشهادة: يحصل الطالب على شهادة عند انهاء المراحل المطلوبةالرسوم: مجانًاالموقع: Alison للتسجيل اضغط هنا
مسببات الأمراض المنقولة بالدم تساعدك هذه الدورة التدريبية حول مسببات الأمراض المنقولة بالدم على معالجة المخاوف الصحية من خلال اكتشاف الجراثيم في دم الناس والاستجابة لها، وهو تدريبٌ مطلوبٌ سنويًا من قبل إدارة الصحة المهنية والسلامة الأمريكية. المدة: مرحلتيناللغة: الإنكليزيةالشهادة: يحصل الطالب على شهادة عند انهاء المراحل المطلوبةالرسوم: مجانًاالموقع: Alison للتسجيل اضغط هنا
المنافسة في السوق في هذه الدورة، سوف تتعلم كيف أن رغبة الشركة في تحقيق أقصى قدر من الربح وسعي المستهلك للحصول على أفضل صفقة يغذي سوقًا دائم التغير. المدة: 5 مراحلاللغة: الإنكليزيةالشهادة: يحصل الطالب على شهادة عند نهاية المراحل ال 5الرسوم: مجانًاالموقع: Alison للتسجيل اضغط هنا
تصميم الرسوم المتحركة المتدرجة والاصطدامية ستتيح لك هذه الدورة الفرصة معرفة كل ما تحتاجه لإنشاء رسوم متحركة عبر ودمج التباين في الرسوم المتحركة المتدرجة والاصطدامية، بالإضافة الى تحميل مساحة العمل حيث ستوضح لك الدورة كيفية إعداد واختيار الألوان من Adobe color. المدة: 4 مراحلاللغة: الإنكليزيةالشهادة: يحصل الطالب على شهادة عند نهاية المراحل ال 4الرسوم: مجانًاالموقع: […]
التعلم الآلي: التطبيقات العملية تقدم هذه الدورة مجموعة واسعة من طرق التعلم الآلي، باتباع نهج عملي للتعلم الآلي في تحليلات الأعمال الحديثة. على مدار الدورة، ستتعامل مع مشاكل العالم الحقيقي أثناء تطبيق نماذج التعلم الآلي على مجموعات البيانات في R، وتفسير التنبؤات، وتقييم هذه التنبؤات لإبلاغ قرارات العمل. اللغة: الإنكليزيةالمدة: 8مراحل (8 أسابيع)الرسوم: مجانًاالموقع: edx […]
مقدمة فلسفية الى المشاعر ستتيح لك هذه الدورة فهم وتحديد أهم الأفكار والمناقشات الفلسفية حول المشاعر، بالإضافة إلى أنها ستوفر لك مصدرًا غنيًا للبيانات حول التحليل العصبي أو النفسي أو الأنثروبولوجي للعواطف. اللغة: الانكليزيةمدة الدورة: 4 أشهر (10 ساعات في الأسبوع)الشهادة: يحصل الطالب على شهادة بعد انجاز المراحل كافةالموقع: Coursera تسجّل الآن
برنامج تحليل البيانات بشهادة محترف سيعلمك هذا البرنامج مهارات البيانات التأسيسية التي يبحث عنها أصحاب العمل لأدوار تحليلات البيانات على مستوى المبتدئين. لن يساعدك ذلك على بدء حياتك المهنية في تحليلات البيانات فحسب، بل سيوفر أيضًا أساسًا قويًا للتطوير الوظيفي المستقبلي في مسارات أخرى مثل علوم البيانات أو الذكاء الاصطناعي أو التعلم العميق أو هندسة […]
اعثر على صوتك المهني: الثقة والتأثير تستهدف هذه الدورة المبتدئين ولكنها يمكن أن تكون بمثابة «ضبط» مفيد لأولئك الذين لديهم بعض الخبرة في هذا المجال أو أولئك الذين يريدون البناء على التعلم السابق. الشرط الأساسي الوحيد هو أن تكون فضوليًا بشأن الصوت في العمل والخطابة. اللغة: الانكليزيةمدة الدورة: 4 مراحل (9 ساعات)الشهادة: يحصل الطالب على شهادة […]
أساسيات التدقيق اللغوي هذه الدورة نقطة انطلاق جيدة إذا كنت ترغب في أن تصبح مصححًا محترفًا لأنها تحدد الأساسيات وتوفر المهارات التي تحتاجها لتحرير المواد الرقمية والمطبوعة قبل النشر. اللغة: الانكليزيةمدة الدورة: 4 مراحلالشهادة: يحصل الطالب على شهادة بعد انجاز المراحل كافةالموقع: Coursera تسجّل الآن
القيادة الدولية والسلوك التنظيمي ستعرفك هذه الدورة على نظرية ممارسة القيادة الدولية والمتعددة الثقافات والسلوك التنظيمي. كشفت أبحاث العلوم الاجتماعية عن طرق منهجية يختلف فيها سلوكنا عبر السياقات الثقافية – مما يمكننا من العمل بشكل أكثر فعالية عبر الحدود. تسمح لنا الرؤى من علم النفس وعلم الأعصاب وعلم الاجتماع والأنثروبولوجيا، ومن دراسات الاتصال ومن المنح […]
مقدمة ستانفورد للغذاء والصحة في هذه الدورة، سيتم تزويد المتعلمين بالمعلومات والمهارات العملية التي يحتاجونها للبدء في تحسين طريقة تناولهم. ستحول هذه الدورة التركيز بعيدًا عن المناقشات الاختزالية حول العناصر الغذائية وتتحرك، بدلاً من ذلك، نحو المناقشات العملية حول الغذاء الحقيقي والبيئة التي نستهلكها فيها. اللغة: الفرنسيةمدة الدورة: أسبوع الشهادة: يحصل الطالب على شهادة بعد انجاز […]
مقدمة الى جداول البيانات تهدف هذه الدورة التمهيدية لجداول البيانات إلى تزويدك بمعرفة المبتدئ للتنقل في كل من جداول بيانات Excel وGoogle حتى تتمكن من تقديم حلول وتنظيم أكبر لأي مشروع. اللغة: الإنكليزيةالمدة: أسبوعالرسوم: مجانًاالموقع: edx للتسجيل اضغط هنا
كيف تتعلم عن بعد تعلم الاستراتيجيات الأساسية للتعلم الناجح عبر الإنترنت.تساعد هذه الدورة المتعلمين الجدد على أنّ يصبحوا ناجحين في التعليم عبر الانترنت حيث تقدم edx استراتيجيات جديدة لتصبح متعلمًا جيدًا عن بعد. اللغة: الإنكليزيةالمدة: أسبوعانالرسوم: مجانًاالموقع: edx للتسجيل اضغط هنا
تحليلات التسويق الرقمي: تحليل البيانات والتنبؤ ورواية القصص هذه الدورة مثالية للمهنيين في وظائف التسويق أو البيانات المستعدين لتوسيع مجموعة مهارات تحليل البيانات الخاصة بهم والحصول على ملاحظة في مؤسساتهم. سيستفيد هؤلاء الأفراد من تركيز الدورة على سرد قصص البيانات لتصور البيانات وتوصيلها إلى أصحاب المصلحة بشكل فعال. المدة: 6 أسابيع (4 الى 6 ساعات […]
غذاء خالي من الغلوتين ستتعلم خلال هذه الدورة كيفية إدارة أمراض الاضطرابات الهضمية والحالات الطبية الأخرى التي يحفزها الغلوتين. تغطي دورة المساعدة الذاتية هذه جميع التقنيات الرئيسية لتحقيق نظام غذائي خالٍ من الغلوتين وتوفر طرق وتوصيات محددة لك لاتباعها ومحاولتها. المدة: 3 مراحلاللغة: الإنكليزيةالشهادة: يحصل الطالب على شهادة عند نهاية المراحل الرسوم: مجانًاالموقع: Alison للتسجيل اضغط […]
نظرية الموسيقى: الشكل الموسيقي في هذه الدورة، ستدرس النماذج الستة في الموسيقى الكلاسيكية من سوناتا أليجرو إلى شكل روندو وكيف تم تشكيل كل نموذج بما في ذلك اختلافاتهم. ستنظر أيضًا في ميزات الآية والجوقة والأنواع الوظيفية الأربعة التي ستظهر في شكل سوناتا أليجرو، وكيف يمكن أن تعود نفس المادة في نقاط معينة في مقطوعة موسيقية، […]
تعلم C++ متقدم أونلاين تعرفك دورة C++ المتقدمة عبر الإنترنت على المفاهيم C++ المتقدمة مثل القراءة المتعددة ومآزق سباق البيانات وغير ذلك الكثير. سيساعدك برنامج C++ التعليمي المتقدم والمجاني على بناء أنظمة التشغيل ومتصفحات الويب والألعاب وما إلى ذلك والعمل معها. اللغة: الإنكليزية المدة: ساعتان الرسوم: مجانًا الموقع: Simple Learn للتسجيل اضغط هنا